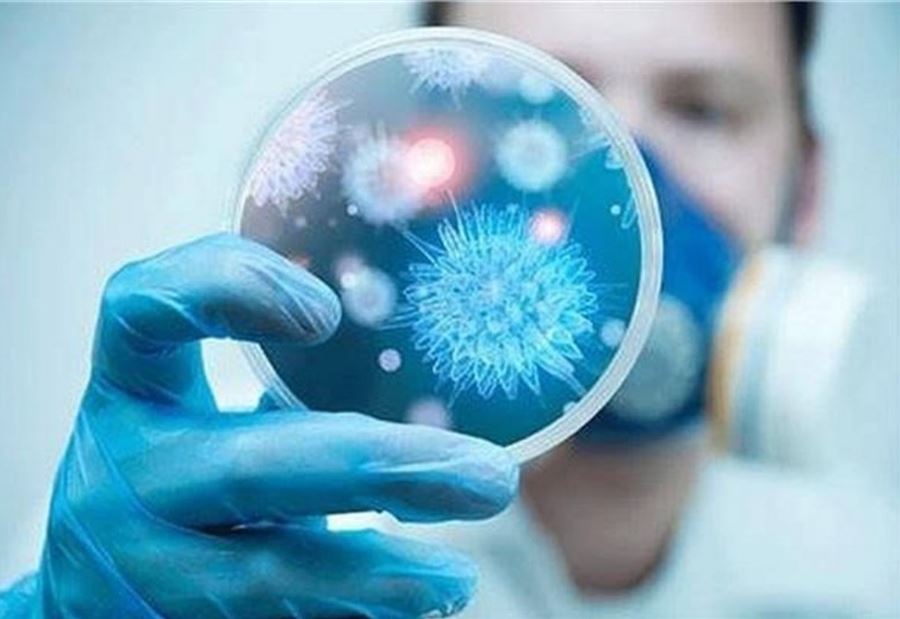

أعلنت مصلحة الابحاث العلمية الزراعية في تل عمارة - رياق، التي تملك مختبرًا متطورًا لفحص الامراض والفيروسات التي تصيب الحيوانات، بيانًا حول فيروس كورونا.
وأشار البيان، الى وجود 5 أنواع من فيروس كورونا هي:
1-الفيروس الذي يصيب الجمال والانسان Mers-cov وهو أخطرهم وموجودٌ في الشرق الاوسط.
2-الفيروس الذي يصيب القطط Seline virus corona.
3-الفيروس الذي يصيب الكلاب Canine virus corona.
4-الفيروس الذي يصيب البقر Bovine virus corona.
5-الفيروس الذي يصيب الانسان Human corona virus.
ولفت، الى أنّ "مختبر الفنار يقوم باتخاذ كافة الاجراءات للتحضر لإجراء الفحوصات للفيروسات الواردة أعلاه".
تــابــــع كــل الأخــبـــــار.
إشترك بقناتنا على واتساب

Follow: Lebanon Debate News

الـــمــــزيــــــــــد
الـــمــــزيــــــــــد





